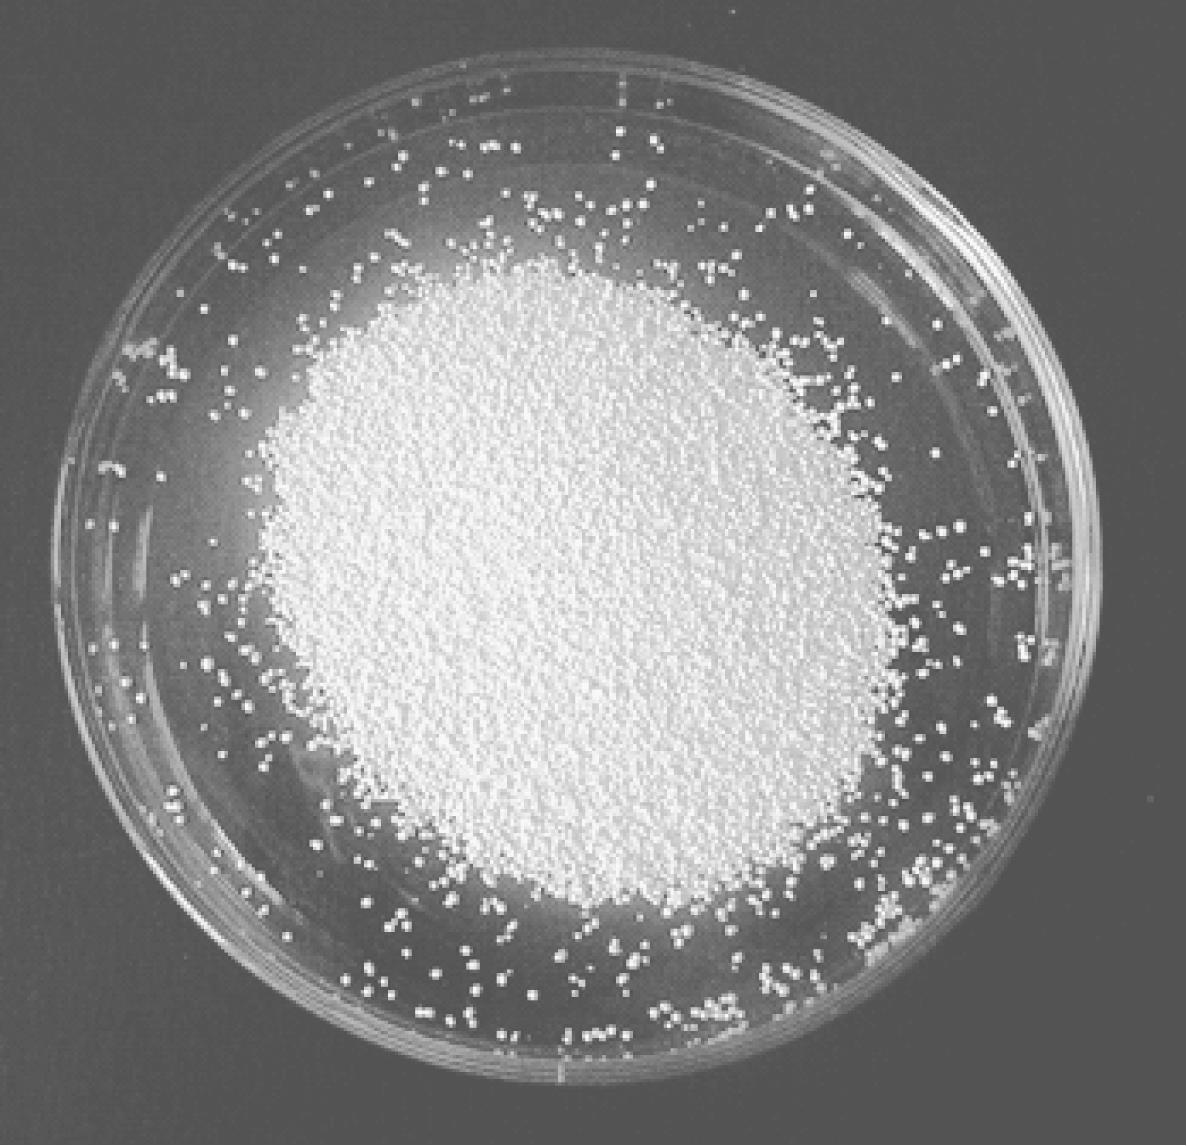

第二节 菜园用药的剂型及使用方法
农药原药加入辅助剂,经过加工制成便于使用的一定药剂形态,叫做剂型。如固体制剂类的粉剂、可湿性粉剂、颗粒剂、片剂等;液体制剂类的乳油、悬浮剂、水剂等。
目前使用的农药大多数是有机合成农药。由工厂生产出来的未经加工的农药叫做原药,原药除少数品种(如液体熏蒸剂)外,绝大多数不能直接在生产上使用。这是因为每亩地上每次施用的原药数量是很少的,要使少量的原药均匀地分散在大面积上,就必须在原药中兑入使之均匀分散的物质,如水、粉等;而绝大多数原药又是不溶于水的。并且施用的农药还应该很好地附着在病虫体或植物体上,以充分发挥药效,但一般原药不具备这样的性能,所以在原药中还应该加入一些辅助剂。这样就需要将原药进行加工,制成一定的药剂形态。
农药经过加工后,制成不同含量和不同用途的产品,这些产品统称为农药制剂。农药制剂通常由3部分组成:农药有效成分的含量、原药的名称和加工的剂型,如3%啶虫脒可湿性粉剂、20%氰戊菊酯乳油。在农药加工制剂或施用过程中,那些能改善药剂理化性质,便于使用或贮藏,有利于增强农药防治效果的辅助物质,统称为农药辅助剂,简称助剂。农药助剂的种类很多,按其用途可分为填充剂、溶剂、湿润剂、乳化剂、分散剂、增效剂、稳定剂和黏着剂等。
农药加工对于提高药效、改善药剂性能、降低毒性及保障安全等方面都起着重要的作用。
一、菜园用药剂型
1. 粉剂
粉剂(dustable powders,代码DP)是一种低浓度粉末状制剂,由农药原药和填料加工而成,是一种较老的剂型,见图1-1。因其加工时粉尘多,运输时成本高,使用时易飘移,造成大部分农药的浪费,且污染环境,故目前市场上粉剂品种较少。它们一般可用于温室大棚的蔬菜病虫害防治,能够在温室大棚内形成飘悬时间比较长的粉尘,扩散性能比较强,能在蔬菜上形成均匀的沉积分布。

图1-1 粉剂
2. 可湿性粉剂
可湿性粉剂(wettable powders,代码WP)是一种能被水润湿,并能在水中分散悬浮的粉末状剂型,在农药剂型和制剂中占有很重要的地位,其产量占全部农药产品的1/4以上,见图1-2。它有较好的生物活性,对于有些难溶于有机溶液,无法加工为乳油的原药,可加工成可湿性粉剂。其有效成分含量较一般的粉剂高,性能优于粉剂,兼有在运输、包装、使用环节更为安全、方便的优点。其缺点是容易引起产品黏结,不易在水中分解,以致喷洒不匀,甚至使植物局部产生药害;并且悬浮率和药液湿润性在经过长期存放和堆压后均会下降。

图1-2 可湿性粉剂
可湿性粉剂主要组成为农药原药、湿润剂、分散剂、填料等,有些品种还需要加稳定剂、警戒色等其他助剂。
该剂型可供喷雾使用,也可灌根、泼浇用,但不能直接作喷粉用。
3. 可溶性粉剂
可溶性粉剂(soluble powders,代码SP)是指由水溶性农药原药和少量水溶性填料混合粉碎而成的水溶性制剂,见图1-3。外观类似可湿性粉剂,但与可湿性粉剂相比,这种制剂不存在喷雾时的药剂微粒沉降不均匀问题,也不会堵塞喷头;与乳油相比,药效相近,且它为固体剂型,可用塑料薄膜或水溶性薄膜包装,可节省包装费和运输费。可溶性粉剂浓度高,其有效成分含量可达60%~90%,贮存时化学稳定性好,相对安全。

图1-3 可溶性粉剂
可溶性粉剂一般由原药、填料和适量的助剂组成。
该剂型在使用方法上与可湿性粉剂、乳油相似。
4. 乳油
乳油(emulsifiable concentrates,代码EC)是一种常用的农药剂型,入水后分散成均相液体,见图1-4。乳油在我国农药市场的份额非常大,占60%以上。它具有药效高、使用方便、性质稳定、容易加工等优点;它的湿润性、黏着性、渗透性和残效期均优于可湿性粉剂。但含有对环境污染较大的有机溶剂,对植物易产生药害,贮运时也不安全。

图1-4 乳油
该剂型主要由农药原药、乳化剂、有机溶剂(或不用溶剂)组成,在某些乳油中还需要加入适量的助溶剂、增效剂、渗透剂和稳定剂等辅助剂,常用溶剂有甲苯、二甲苯等。
当乳油被稀释成乳剂后,短时间内不发生油水分离现象。若乳油在贮存时遇低温出现结晶或絮凝,可视具体情况决定是否能够使用。当有些农药品种的有效成分在有机溶剂中的溶解度随着气温的降低而下降,有可能会有原药结晶析出。出现这种情况,若该乳油在使用时结晶能够自动重新溶解,则可以正常使用;而当乳油中出现絮凝物时,多是由于农药原药或溶剂中含有杂质所致,摇动后能够消失则可正常使用。
乳油除兑水稀释喷雾使用外,也可作涂茎、灌根、拌种、浸种等使用。
5. 悬浮剂
悬浮剂(aqueous suspension concentrates,代码SC)又称水悬浮剂或胶悬剂,是一种不溶于水的固体原药分散悬浮在含有多种助剂的水相介质中的胶状液体制剂,见图1-5。由于悬浮剂没有像可湿性粉剂那样的粉尘飞扬问题,不易燃易爆,粒径小,生物活性高,密度较大,包装体积较小,相对其他农药剂型安全环保、使用方便,因此,悬浮剂已成为水基化农药新剂型中吨位较大的农药品种。但是,悬浮剂也有一定的不足之处,如助剂系统较为复杂,配方研制较为繁琐,且悬浮剂有一定的黏性,易附着于包装物上,造成用药时的计量困难。

图1-5 悬浮剂
该剂型制剂包括固体原药、水和多种助剂,如分散剂、增稠剂、湿润剂、稳定剂、防冻剂、消泡剂、防腐剂、pH值调整剂等。
该剂型使用时兑水喷雾即可。
6. 水分散粒剂
水分散粒剂(water dispersible granules,代码WG)又称干流动剂、水悬性颗粒剂,是一种入水后能迅速崩解,分散成悬浮液的粒状农药剂型,见图1-6。它是在可湿性粉剂和悬浮剂的基础上发展起来的新剂型,它具有分散性好、悬浮率高、稳定性好、使用方便、有效成分含量高(有的高达90%)等特点,避免了可湿性粉剂产生粉尘、悬浮剂包装运输不便、贮藏易产生沉淀、结块、流动性差、粘壁等缺点。
图1-6 水分散粒剂
该剂型的组成有农药原药、助剂及少量填料。助剂有分散剂、湿润剂、崩解剂、消泡剂、黏结剂、防冻剂等。
该剂型的使用与悬浮剂同。
7. 微乳剂
微乳剂(microemulsions,代码ME)是农药有效成分和乳化剂、分散剂、防冻剂、稳定剂、助溶剂等助剂均匀地分散在水中,形成透明或接近透明的均相液体,见图1-7。

图1-7 微乳剂
该剂型由液态农药、表面活性剂、水、稳定剂等组成。其特点是以水为介质,不含或少含有机溶剂,因而不燃不爆,生产操作、贮运安全,环境污染少,节省大量有机溶剂;农药分散度极高,达微细化程度,外观近似于透明或微透明液体;在水中分散性也好,对靶体渗透性强,附着力好。由于添加了大量的表面活性剂,一般田间药效比乳油高5%~10%。但是,由于微乳剂自身结构特点,注定了微乳剂中有效成分含量一般最高仅有25%左右。
8.水剂
水剂(aqueous solutions,代码AS)是将水溶性原药直接溶于水中而制成。一般情况下,用于加工水剂的农药原药应易溶于水,且水溶液化学稳定性好,见图1-8。为了使水剂喷洒在植物表面有一定的展着性,常加入湿润剂作为助剂。与乳油相比,水剂加工时不需要有机溶剂,仅需加适量的表面活性剂,而药效与乳油相当。水剂的成本低,但有的农药品种不稳定,不耐贮藏,易于水解失效,湿润性差,附着力弱,持效期也很短。

图1-8 水剂
该剂型使用时加水稀释到所需浓度即可喷施。
9. 烟剂
烟剂(smokes,代码FU)是一种引燃后有效成分以烟状分散体系悬浮于空气中的粉末状农药剂型,见图1-9。点燃后燃烧均匀,无明火,发烟率高,主要用于设施(如温室、塑料大棚)内蔬菜病虫害的防治。烟剂的使用工效高,不需任何器械,不需用水,简便省力。

图1-9 烟剂
烟剂由原药、燃料(木屑粉、淀粉等)、助燃剂(如氯酸钾、硝酸钾等)、阻燃剂(如陶土、滑石粉等)制成。它需加工制成一定的形状或采取一定的充填方式,较通用的有烟雾罐、烟雾烛、烟雾筒、烟雾棒、烟雾片等。
该剂型使用时点燃,可燃烧,但只发烟而没有火焰,其有效成分因受热而气化,在空气中冷却又凝结为固体微粒,直径达0.1~2μm。沉积到植物上的烟粒不但对害虫有良好的触杀和胃毒作用,而且空气中极微小的烟粒还可通过害虫的呼吸道进入虫体而杀死害虫。
10. 粒剂
粒剂(granules,代码G)是由原药、载体和助剂加工而成的粒状农药剂型,见图1-10。该剂型的优点是:①使高毒农药低毒化使用,如有的农药在禁止喷雾使用的情况下,可加工成颗粒剂,采用穴施、撒施等方法使用,用来防治害虫;②可控制有效成分释放的速率,延长持效期;③使液态药剂固态化使用;④降低药害出现概率,减少环境污染,避免伤害有益昆虫;⑤使用方便,提高劳动效率,但粒剂加工费一般比粉剂高,多数情况下使用方法也受到一定的限制。

图1-10 颗粒剂
粒剂按颗粒的大小可分为:大粒剂(粒径5000~9000μm)、颗粒剂(粒径297~1680μm)、微粒剂(粒径74~297μm)。
粒剂中的原药有的是固体,有的是液体;其中的载体可承载原药,无生物活性,如硅石、硅砂、沸石、珍珠石等;而辅助剂按作用可分为黏结剂、吸附剂、湿润剂、稳定剂和着色剂等。
11. 水乳剂
水乳剂(emulsion oil in waters,代码EW)是将不溶于水的农药原药先溶解在与水不相容的溶剂中,然后再分散到水中,形成的一种热力学不稳定分散体系的剂型,见图1-11。

图1-11 水乳剂
水乳剂用大量的水取代了芳香烃类有机溶剂,所添加的黏度调节剂一般从食品添加剂中选取,是国际公认的对环境安全的农药新剂型。与乳油相比,水乳剂减少了对环境的污染,降低了着火的可能性,减少了对人畜的毒性和刺激性及对作物的药害。但水乳剂仍含有部分有机溶剂,仍存在着完全隐患,且加工过程复杂。
12. 缓释剂
缓释剂(controlled release formulations,代码CRF)是可以控制农药有效成分从加工品中缓慢释放的农药剂型,是具有控制释放能力的各种剂型的总称,见图1-12。缓释剂具有延长农药的持效期、减少施药次数、降低用药量和药剂的使用毒性等优点。虽然加工缓释剂可能会提高生产成本,但带来的经济、社会和生态效益是很可观的。

图1-12 缓释剂
缓释剂依据其加工方法可分为物理型缓释剂和化学型缓释剂两大类。物理型缓释剂主要是利用包衣封闭与药剂渗透、贮存体吸附与药剂扩散、药剂与贮存体溶解固化和药剂解析等基本原理制成;化学型缓释剂是使带有羟基、羧基或氨基等活性基团的农药与一种有活性基团的载体,经过化学反应结合到一起而制成的。
13. 可分散片剂
可分散片剂(water dispersible tablet)是指遇水可迅速崩解,形成均匀混悬液的片剂,是国外近年来研究较热门的一种新型制剂。它集中了在水中自动崩解、形成悬浮液、供喷雾使用的泡腾片剂与水分散粒剂、吸潮分解熏蒸毒杀害虫的片剂的优点于一身;又吸收了片剂的外形特点,见图1-13。因此,可分散片剂较水分散粒剂对环境更安全,保持了泡腾片剂的崩解速率快、水分散粒剂悬浮率高的优点,使其在保证药效不降低的前提下对环境和施药者更安全,没有粉尘,减少了对环境的污染。由于可分散片剂具有上述诸多优点,因此近年来得到了较快的发展。

图1-13 可分散片剂
除以上介绍的剂型外,生产中根据不同的需求,还有气雾剂、膏剂、毒饵等剂型。
二、菜园用药使用方法
要把农药施到目标物上可以采用多种施药技术,目前常用的有喷粉法、喷雾法、种苗处理法、撒颗粒法、熏蒸法、烟雾法、毒饵法、涂抹法等多种。随着科学技术的进步、生产的需求和人们环保意识的增强,施药方法也在不断地改进和完善。
使用农药防治有害生物,目的是要用最少的农药获得最佳的防治效果,且不能引起人畜中毒和环境污染,这就要求在使用农药时,不仅要考虑到农药的种类、剂型和药量,还要考虑到植物生态、防治对象、施药环境及选择的施药工具等,经过归纳综合、分析筛选,确定最佳的施药方法。
1. 喷粉法
喷粉法是利用机械产生风力把粉剂吹散,使粉粒覆盖在靶标及作物表面,并要求药粉能在靶区产生有效沉积,以达到较好的田间防治效果。喷粉法的主要优点是工效高,作业不受水源限制,在干旱、缺水地区更具有应用价值。细粉粒的药效好、沉积覆盖也比较均匀。缺点是粉粒飘移性强、易污染环境,所以喷粉法的使用越来越受到限制,目前在封闭的大棚、温室内还有一些应用。
喷粉法按采用的施药手段可分为手动喷粉法、机动喷粉法、粉尘法、静电喷粉法等。
(1)手动喷粉法 利用手摇喷粉器进行喷粉的方法。图1-14为生产中常用的一种手动喷粉器——丰收-5型喷粉器的内部结构。喷粉时,药桶装粉前,先把开关关上,药粉不可装满,一般不超过药桶体积的3/4,黏重的药粉还应更少些,以便空气流通。转动摇柄的速度要快慢一致,一般为30~35r/min,喷粉管应放平,或稍向前下方倾斜,以利于药粉排出。

图1-14 丰收-5型喷粉器结构
1—搅拌器;2—药粉桶;3—松粉盘;4—桶盖;5—开关盘;6—手柄
(2)机动喷粉法 使用背负式弥雾喷粉机或拖拉机喷粉机进行田间喷粉的施药方法。图1-15为背负式机动喷粉机的内部结构。目前主要使用背负式弥雾喷粉机。喷粉时有直管和长塑料薄膜管喷撒之分。直管喷撒适用于短距离喷粉,长塑料薄膜管喷撒适用于较大范围的喷粉。

图1-15 背负型机动喷粉机结构
1—叶轮;2—风机壳;3—出风筒;4—吹粉管;5—粉门体; 6—输粉管;7—弯头;8—喷管
(3)粉尘法 在封闭的温室、大棚等菜地进行的手动喷粉的一种特殊形式。粉尘法所用的粉剂必须通过325目标准筛,粉粒的粒度有50%以上小于20μm。图1-16为大棚内采用粉尘法施药。

图1-16 粉尘法施药
在温室、大棚中采用粉尘法施药时,只需沿直线从里面一端慢慢走向外面一端,喷粉管平直或稍上,不可把喷粉器的喷口对准植物进行喷撒。否则,不但喷撒沉积不均匀,而且容易引起粉剂堆积过多,浪费用药或引发药害。
晴天采用粉尘法施药,最好选择在傍晚进行,因为在阳光较强时喷粉,叶片表面“热致迁移现象”比较强,细粉沉积时间过长,不容易很快沉积在叶片上。闭棚太久时,叶面出现结露后也不宜喷粉,因为叶面有露水时粉尘扩散分布受阻,粉尘的沉积均匀性会降低。
(4)静电喷粉法 在用静电喷粉机进行喷粉时,通过喷头的高压静电给农药粉粒带上电荷,又通过地面给作物的叶片和叶片上的害虫带上相反的电荷,靠这两种异性电荷的相互吸引力,把农药粉粒紧紧地吸着在叶片上或害虫体上,其附着量比常规非静电喷粉的多5~8倍。图1-17为静电喷粉机。粉粒越细小,越容易附着在叶片和害虫体上。

图1-17 静电喷粉机
天气对静电喷粉的效果有一定的影响。一般说气温的影响不大,但空气湿度的影响比较大。潮湿能使粉粒带电量减少,且易失去电荷;风力能影响静电喷粉的效果,在风速1.5~2.5m/s的情况下,随着风速的增加,靶标作物上附着药剂的量逐渐减少,风速达到3m/s以上,则影响更大。因而应选择在无风或风力很小的晴天进行静电喷粉。
2. 喷雾法
喷雾法是将乳油、悬浮剂、胶悬剂、可溶性粉剂、水剂或可湿性粉剂等农药制剂,兑入一定量的水,混合调制后,即成均匀的乳状液、溶液或悬浮液等,利用喷雾器使药液形成微小的雾滴。其雾滴的大小,随喷雾水压的高低、喷头孔径的大小和形状、涡流室大小而定。通常水压越大、喷头孔径越小、涡流室越小,则雾化出来的雾滴直径越小,雾滴覆盖密度越大。且由于乳油、悬浮剂、胶悬剂和可湿性粉剂等的展着性、黏着性比粉剂好,不易被雨水淋失,持效期长,与病虫接触的机会增多,其防效也会越好。
喷雾法的优点是药液可直接接触防治对象,而且分布均匀,见效比较快,防效比较好,方法简单,容易操作。其缺点是药液容易飘移流失,药液易沾污施药人员而引起中毒,并受水源限制。
影响喷雾效果的因素很多,主要归纳为以下几个方面。
①农药的理化性能,如液滴在固体表面的湿展性。
②药械对药液的雾化情况。
③生物表面的结构特点,如同种药液对茸毛多、蜡质层厚的叶面不易湿展,而对茸毛少、蜡质层薄的叶面则较易湿展。
④药液在不同昆虫体壁上湿展的差异往往也很大,如某些害虫具有保护层和厚蜡质层,一般药液很难在其体表湿展。
⑤水质对药液也有影响,如水的硬度大小。硬水对乳液和悬浮液的稳定性破坏作用很大,有的药剂在硬水中可能转变成非水溶性或难溶性的物质而丧失药效;有些水的硬度大,碱性亦大,一些药剂易被碱分解,严重影响药效。
⑥喷雾时遇大风,喷后遇雨,也影响喷雾效果。
喷雾法是当前使用最广泛的施药方法,发展很快,具体方法很多,在实际生产应用中,通常采用常量喷雾法。
常量喷雾法又称高容量喷雾法,常用的剂型一般为乳油、可湿性粉剂、悬浮剂、可溶性粉剂和水剂等,这些制剂的有效成分含量在20%~80%,每公顷药液量一般为450~1500L,常用压力一般为3~4kgf/cm2(1kgf/cm2=98.0665kPa),喷出的雾滴直径为150~1200μm。常量喷雾与喷粉相比,具有附着力强、药效期长、效果好等优点。但是存在着工效低、劳动强度大、药液易流失浪费、用水量多、污染土壤和环境等缺点。
从常量喷雾所用的动力来分,菜园常用的有手动喷雾法和机动喷雾法。
(1)手动喷雾法 是以手动方式产生的压力使药液通过液力式喷头喷出,与外界静止的空气相冲撞而分散成为雾滴的施药方法。图1-18为背负式手动喷雾器。它是我国蔬菜病虫害防治中最普遍采用的喷雾方法。

图1-18 背负式手动喷雾器
手动喷雾法操作时,根据操作人员的体力,喷雾时喷雾器一般应保持在196~294kPa的压力,即气室的液面应保持在水位线上下,这样才能保持喷头雾化良好。喷洒时喷头应保持离开作物50cm左右。一方面是为了避免雾滴对作物的冲击力量过大,使药液更容易流失,另一方面在靠喷头近处雾化过程尚未充分完成,雾滴较粗大,会呈流水状淌流,药液洗株。在作物生长到中后期,常使喷头向上,使药液能喷到叶背。在进行田间作业时要避免人体从已经喷过药的作物中穿过,否则会大量撞落药水,办法是退行喷雾或一侧喷雾。
(2)机动喷雾法 是以机械或电力作为雾化或喷洒动力的喷雾方法。图1-19为机动喷雾机。对于大面积菜园的病虫害防治,可以采用此种喷雾器械,其优点是工作压力大、射程远、雾滴细、工作效率高,大大降低了劳动强度。菜园病虫害防治时,应根据菜园面积、防治对象、作物品种、高矮、行距等选择适宜的机动喷雾机。

图1-19 机动喷雾机
在实际生产中,喷雾时还应注意如下问题。
①喷药前要检查喷雾器是否漏气、漏水,动力喷雾器是否有油,用清水进行试喷。喷药人员要穿好防护服,戴好帽子、口罩、手套、风镜等安全防护品。
②选择适宜的气候条件,即在无风或微风晴天进行,风速超过三级以上停止喷洒;有风时要从上风头向下风头喷洒;高温干旱的天气应选在上午9时前、下午3时后喷洒;中午不要喷药;早晚施药时,应等无露水时再喷洒;刚下过雨不要进行茎叶喷雾;作物开花盛期最好不要喷药。
③依据作物长势、气温、土壤含水量等,选择适宜的水质和用水量。一般原则是,茎叶喷洒比土壤处理喷洒用水量少;幼苗期比成株期用水量少;高温干旱时用水量适当加大一些;土壤含水量低时用水量大;密植作物和高大作物比稀植和矮棵作物用水量大。具体用水量应依据各种农药的使用说明书,按上述情况确定,但不能随意减少规定的用水量,否则防效差,尤其是采用土壤处理法防除农田杂草。一般亩(1亩=667m2)用水量,用常规喷雾器不能低于30kg/亩(450kg/hm2)。茎叶喷洒时,以喷洒均匀、植株叶片上不产生滴液或有少量滴液为宜。不要出现滴液淌流现象,不要因病情重、虫量大、杂草多而多喷药液。结果不仅浪费药液,而且更重要的是造成植株受害,严重的还会引起植株死亡。尤其是生长期喷洒除草剂,绝对要严格掌握喷药量,不要重复喷洒,要按顺序一垄一垄地喷。
3. 土壤处理法
土壤处理法是对土壤表面或耕作层进行药剂处理的一种施药方法。剂型可以是颗粒剂、胶囊剂、微胶囊剂等固态药剂、乳油、悬浮剂等液态药剂,也可以是气体药剂。图1-20为土壤处理操作方法之一。该方法能防治土壤中有害生物、杂草及种子携带的病虫。内吸性药剂经种子、幼芽或根吸收后也能达到杀灭地上有害生物的目的。

图1-20 土壤处理法
土壤处理法包括全面土壤处理和局部土壤处理。全面土壤处理一般指对整块菜地进行喷雾、撒粉、撒粒、浇灌或土壤熏蒸,在播种前进行,这种处理方法对土传性病虫害及杂草的防治比较彻底,但所耗用的农药量也比较大。局部土壤处理是仅对菜地局部地段进行用药的施药方法。
土壤用药时,要考虑到土壤质地、有机质含量、土壤颗粒成分、土壤水分、土壤pH值、土壤微生物等,还有雨水、灌溉水等因素。
4. 种苗处理法
种苗处理法是把药液施在种子和幼苗上的一种施药方法。蔬菜种苗的处理法一般包括拌种法和幼苗浸渍法。
(1)拌种法 用药粉处理种子,让药粉沾到种子上,一般在拌种器中装入种子和称好的药粉,使之以40~50r/min的速度旋转,处理数分钟即可。图1-21为拌种器拌种。也可用一定量的药液与种子拌和后,再堆闷一段时间,使种子收尽药液,这也是拌种的一种方法,多称为湿拌或闷种。

图1-21 机器拌种法
(2)种苗浸渍法 用配好的药液浸渍种子或幼苗的施药方法。通过浸种或浸苗,可以使种子充分吸水,以利催芽播种;可以使种苗吸收农药,防止病虫入侵,杀死种苗内外的病菌或害虫。图1-22为浸种法。用于浸种苗的药剂多为水剂或乳油、悬浮剂,也可以用可湿性粉剂。浸种时,药液用量以浸没种粒为限。浸种药剂可连续使用,但要及时补充所减少的药液量。浸种温度一般要在10~20℃,温度高时就适当降低药液浓度或缩短浸种时间。

图1-22 浸种法
5. 熏蒸法
利用药剂产生有毒的气体,在密闭的条件下,用来消灭一些病害或具有较强迁移能力、隐蔽性强、不易被发现的害虫等。图1-23为温室内的熏蒸法。例如,如用敌敌畏制成毒杀棒施放在蔬菜枝杈上,可以熏杀白粉虱、烟粉虱、潜叶蝇等害虫。

图1-23 熏蒸法
实施熏蒸防治应该在密闭空间或相对密闭的环境下进行,如防治温室、大棚蔬菜上的病虫害。防治土壤中的病虫害时一般需要覆膜,熏闷一段时间,再放风3~5天才可再用,以免对植物产生药害。
6. 熏烟法
利用烟剂产生的烟雾来防治有害生物的施药方法(图1-24)。此法适用于防治虫害和病害,鼠害防治有时也可采用此法,但不能用于杂草防治。烟是悬浮在空气中的极细小的固体微粒,其重要特点是能在空间自行扩散。在气流的扰动下,能扩散到更大的空间中和更远的距离,沉降缓慢,药粒可沉积在靶体的各个部位,包括植物叶片的背面,因而防效较好。

图1-24 熏烟法
熏烟法的优点是使用方便、工效高、不增加湿度;缺点是易污染环境。此法主要应用在封闭的小环境中,如温室、塑料大棚。如果是大面积的高棵菜地,也可以考虑用熏烟的方法来防治病虫害。在露地影响熏烟药效的主要因素是气流,与熏烟有关的气流因素有以下几个。
(1)上升气流 上升气流使烟向上部空间逸失,不能滞留在地面或作物表面,所以白昼不能进行露地熏烟。
(2)逆温层 日落后地面或作物表面便释放出所含的热量,使近地面或作物表面的空气温度高于地面或作物表面的温度,有利于烟的滞留而不会很快散逸,因此在傍晚和清晨放烟易取得成功。
(3)风向风速 风向风速会改变烟云的流向和运行速度及广度,在风较小时放烟能取得较好的防效。
(4)海风和陆风 在邻近水域的陆地,早晨风向自陆地吹向水面,谓之陆风;傍晚风向自水面吹向陆地,谓之海风。在海风和陆风交变期间,地面出现静风区,此时放烟效果较好。
(5)地形 烟容易在低凹地、阴冷地区相对集中。
研究利用上述气流和地形地貌,可以成功地在露地采用熏烟法防治蔬菜病虫害。
7. 施粒法
施粒法是指将颗粒剂撒施到一定范围内以防治植物病虫害的施药方法。对毒性高或易挥发的农药品种,不便采用喷雾和喷粉的方法,可以制备成颗粒剂来撒施。图1-25为徒手抛撒低毒农药颗粒剂。粒剂的颗粒粗大,撒施时受气流的影响很小,容易落地而且基本上不发生飘移现象。撒施可采用多种方法,如徒手抛撒(低毒药剂)、人力操作的撒粒器抛撒、机动撒粒机抛撒、土壤施粒机施药等。

图1-25 徒手施粒
8. 毒饵法
毒饵法是利用农药和害虫等有害动物喜食的饵料配制成毒饵,并同时撒到一定的场所,来毒杀害虫等有害生物的一种施药方法。图1-26为毒饵法诱到的害虫。该法适用于诱杀具有迁移活动能力、咀嚼取食的有害动物,如害鼠、害虫、蜗牛、蛞蝓等。

图1-26 毒饵法诱虫
毒杀害虫常用的饵料可用豆饼、花生饼、麦麸等,用药量一般为饵料的1%~3%;也可用鲜水草或野菜,药剂用量一般为饵料的0.2%~0.3%。
9. 涂抹法
涂抹法是将药液涂抹在植株的某一部位上的一种施药方法,如图1-27所示。一般蔬菜上应用较多的是植物生长调节剂,如用药剂涂抹瓜果类的花器,可以保花、保果,提高坐果率。涂抹法能集中用药,省药,减少污染,但费工。

图1-27 激素涂抹